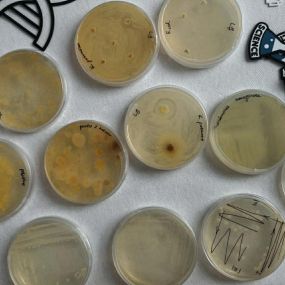

Aktualności
Dzień Otwarty Uniwersytetu Rzeszowskiego
Wydział Biotechnologii miał ogromną przyjemność zaprezentować się podczas tego wyjątkowego wydarzenia. Nasze stoisko z pokazami, przygotowane przez:
cieszyło się dużym zainteresowaniem – dziękujemy za wszystkie rozmowy, pytania i wspólnie spędzony czas!
Uczestnicy mogli również wziąć udział w inspirujących wykładach:
dr Leszek Potocki – „Paradoks wirusa: wróg naszego wroga jest naszym przyjacielem – od zwalczania lekooporności po monitoring sanitarny wód”
dr Karol Skrobacz – „Dlaczego babcia kłamie (ale mówi prawdę), twierdząc że ogórki z jej działki są ekologiczne?”
prof. dr hab. Idalia Kasprzyk – „Mikroślady środowiskowe”
dr Mateusz Rybak – „Inne spojrzenie na glony”
Dziękujemy wszystkim odwiedzającym za obecność i zainteresowanie biotechnologią.
Mamy nadzieję, że do zobaczenia już wkrótce – być może jako przyszli studenci!